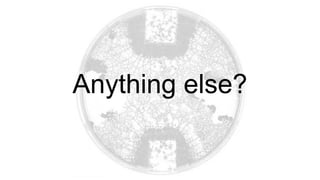
Anything else?

The document discusses the current hardware landscape for deep learning, highlighting the predominance of GPUs, the emergence of TPUs and FPGAs, and advancements in neuromorphic and quantum computing. It details various CPU and GPU architectures, memory speed, and the performance impact of different computing instructions optimized for machine learning tasks. Additionally, the document covers the evolution of deep learning libraries and infrastructure, emphasizing the need for energy efficiency and suitable architectures for deep learning applications.




![Typically multi-core even on the desktop market:
● usually from 2 to 10 cores in modern Core i3-i9 Intel CPUs
● up to 18 cores/36 threads in high-end Intel CPUs
(i9–7980XE/9980XE/10980XE) [https://en.wikipedia.org/wiki/List_of_Intel_Core_i9_microprocessors]
● up to 32 cores/64 threads in AMD Ryzen Threadripper
(seems to be the same for the 3rd gen
https://www.anandtech.com/show/14994/first-details-about-3rd-generation-ryzen-threadripper-32-cores-280-w)
x86: Desktops](https://image.slidesharecdn.com/deeplearning-hardwarelandscape-191201174744/85/Deep-learning-Hardware-Landscape-5-320.jpg)
















































































![Neuromorphic chips: Intel Loihi
“Intel researchers have recently been testing the Loihi chip by
training it on tasks such as recognizing a small set of objects
within seconds. The company has not yet pushed the capabilities
of the neuromorphic chip to its limit, Mayberry [Michael Mayberry,
corporate vice president and managing director of Intel Labs]
says. Still, he anticipates neuromorphic computing products
potentially hitting the market within 2 to 4 years, if customers
can run their applications on the Loihi chip without requiring
additional hardware modifications.”
“Neither quantum nor neuromorphic computing are going to
replace general purpose computing,” Mayberry says. “But
they can enhance it.”
https://spectrum.ieee.org/tech-talk/computing/hardware/intels-49qubit-chip-aims-for-quantum-supremacy](https://image.slidesharecdn.com/deeplearning-hardwarelandscape-191201174744/85/Deep-learning-Hardware-Landscape-86-320.jpg)